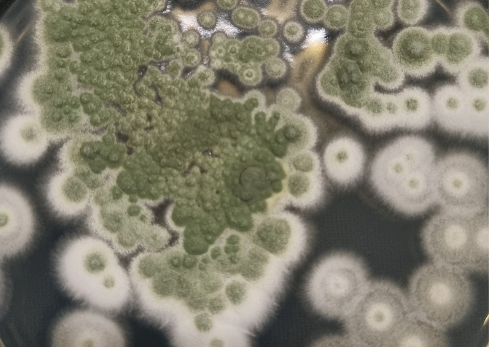

Modo de acción
Tras la aplicación, Meta-Turbo® inicia la infección mediante la adhesión de los esporos a la superficie del insecto objetivo. Los esporos germinan y penetran la cutícula del insecto utilizando enzimas y compuestos químicos que degradan las capas externas del exoesqueleto. Una vez dentro, el hongo se desarrolla por todo el cuerpo del insecto, multiplicándose rápidamente, consumiendo los nutrientes del hospedero y causando daños a su sistema fisiológico, lo que finalmente resulta en la muerte de la plaga.
Incluso después de la muerte del hospedero, Metarhizium anisopliae IBCB 425 continúa su ciclo reproductivo, formando estructuras de esporulación con conidios capaces de infectar a otros insectos presentes en el área, proporcionando un efecto residual en el control biológico de plagas.
Aplicación
Aplicación terrestre:
La aplicación debe realizarse con pulverizador manual, pulverizador de barra tractorizado y/o autopropulsado, calibrado para operar con presión y volumen de mezcla constantes. Debe estar equipado con boquillas que reduzcan la deriva y promuevan una cobertura uniforme, siguiendo las recomendaciones del fabricante, con filtros de malla 50. Aplicar un volumen de mezcla de 80 a 300 L/ha.
Aplicación aérea:
Para aplicaciones foliares, utilizar aeronave agrícola equipada con boquillas de pulverización o atomizadores rotativos que garanticen una cobertura homogénea, siguiendo las recomendaciones del fabricante. Aplicar un volumen de mezcla de 30 a 60 L/ha. Para esta modalidad, se recomienda el uso del coadyuvante Naft® en la dosis de 50 a 100 mL/ha.
Aplicación con drones:
Para aplicaciones foliares, utilizar drones agrícolas de pulverización equipados con boquillas de pulverización o atomizadores rotativos que garanticen una cobertura homogénea, según las recomendaciones del fabricante. Aplicar un volumen mínimo de 20 L/ha. Para esta modalidad, se recomienda el uso del coadyuvante Naft® en la dosis de 50 a 100 mL/ha.
Seguir las recomendaciones de tecnología de aplicación proporcionadas por el agrónomo responsable.
Precauciones generales
Producto de uso exclusivamente agrícola. PRODUCTO NO CLASIFICADO y POCO PELIGROSO PARA EL MEDIO AMBIENTE (CLASE IV). Consulte siempre a un ingeniero agrónomo y siga correctamente todas las instrucciones. Es importante optar por el manejo integrado de plagas. Lea la etiqueta y asegúrese de que quien manipule el producto pueda comprenderla. Para manipular el producto, utilice los equipos de protección individual especificados en la etiqueta y en la hoja técnica. Los envases deben destinarse a las unidades de recepción de inpEV.

Productos relacionados
Consulte a continuación algunos productos relacionados
Noticias
Consulte nuestras últimas publicaciones

13/05/2026 - Vittia na mídia
25% das sementes comercializadas no Brasil, em média, já são tratadas com produtos biológicos
Durante o ENSOJA 2026, em Foz do Iguaçu, Ronaldo Beneduzzi, nosso Gerente da Divisão..

09/03/2026 - Notícias da Imprensa
MAPA renova Selo Mais Integridade da Vittia
Premiação do MAPA é reconhecimento às empresas que desenvolvem práticas de ética, sustentabilidade, integridade..

12/02/2026 - Notícias da Imprensa
Vittia lança websérie em celebração aos 55 anos sobre propósito, legado e futuro
A Vittia, empresa brasileira referência em soluções para a agricultura, lança uma websérie documental..

16/01/2026 - Notícias da Imprensa
Vittia celebra 55 anos de inovação para uma agricultura sustentável e de alta performance
A Companhia apresenta ao mercado seu novo posicionamento –Sou Raiz, Sou Vittia– e a..

03/11/2025 - Notícias da Imprensa
CONVITTIA reforça a estratégia da Vittia de proximidade e de escuta ativa do campo
Com o conceito “escutamos quem vive o agro todos os dias”, a iniciativa estreita..
Preguntas frecuentes
Respuestas claras para ayudarle a entender mejor el uso y los beneficios de nuestros productos.
¿Qué es Meta-Turbo® y cuál es su función?
Meta-Turbo® es un insecticida microbiológico a base del hongo Metarhizium anisopliae IBCB 425, utilizado en el control de salivazos. Es una alternativa sostenible a los insecticidas químicos, con excelente desempeño en campo y seguridad ambiental.
¿Qué significa la formulación WP (polvo mojable)?
La sigla WP significa “Wettable Powder”, o polvo mojable. Es una formulación sólida, seca y estable que solo se vuelve líquida y aplicable cuando se dispersa en agua, formando una suspensión para el proceso de aplicación.